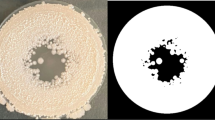

Abstract
ENDOTROPHIC sporulation occurs when an organism, forms spores in a medium lacking substances necessary for growth. It was of interest to determine whether a group of growth-inhibitory substances also inhibited sporulation.
Similar content being viewed by others
Article PDF
References
Brock, T. D., Bact. Revs., 25, 32 (1961).
Cooper, P. D., Bact. Revs., 20, 28 (1956).
Brock, T. D., Science, 136, 316 (1962).
Anand, N., and Davis, B. D., Nature, 185, 22 (1960).
Author information
Authors and Affiliations
Rights and permissions
About this article
Cite this article
BROCK, T. Inhibition of Endotrophic Sporulation by Antibiotics. Nature 195, 309 (1962). https://doi.org/10.1038/195309a0
Issue date:
DOI: https://doi.org/10.1038/195309a0